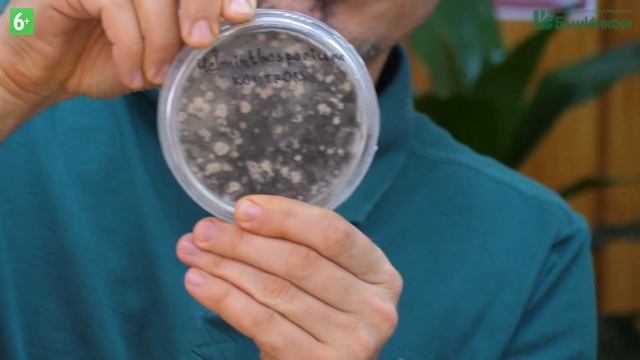
Октябрина Ганичкина в БашИнкоме смотреть онлайн

Автор / Канал: Тайное саморазвитие Страница 3

Зима. Вьюга. Снежная метель.

Изучать французский язык во сне ||| Самые важные французские фразы и слова ||| (2)

Проснулись лягушки во дворе

{??/??}React«The Birth of a Hero»on «The Unfortunate Demon»r.d. Реакция«РГ»на«Несчастный демон»ч.о.

США.Цены на телевизоры в Америке.Черная пятница в Best Buy и Target.

Раскрутка страницы в Инстаграм. Шилкина Гульнара

А Ваш ребенок хочет делать уроки?

КОТЛЕТЫ ИЗ ПШЕНА простой и очень вкусный рецепт

СПАТЬ ПОД ЗВУКИ ЛЕСА И ПЕНИЕ ПТИЦ Видео для быстрого засыпания

Как я опозорился у всех на глазах (Анимация)

ТОП-10 ПРИЧИН для употребления МЯТНОГО чая РЕГУЛЯРНО
Октябрина Ганичкина в БашИнкоме

Мы одно целое дерево жизни . #видение

Экспресс-диагностика речи в 5 лет.

Видео с милахой??

Любить не страшно, страшно ждать... | Склифосовский | Марина| Олег

Феттель против Леклера l Формула 1 l Обзор сезона 2019

Шум водопада и чилаут музыка для расслабления | Waterfall, chillout

Кусты Розы цветут, цветение Роз (красные розы) лето 2017

Из жизни белок . Красивая музыка.

Новорожденные Котята Хотят Сбежать

КАК МОЙ ДОМ ПРОВАЛИЛСЯ ПОД ЗЕМЛЮ В МАЙНКРАФТЕ ?! - ТРОЛЛИНГ ЛОВУШКА В MINECRAFT

Отрывок из пьесы А.Н. Островского " Старый друг, лучше новых двух"

Красивое пожелания спокойной ночи!
За каждым успешным каналом стоит личность, идея и сотни часов кропотливого труда. Если вы здесь, значит, автор «Тайное саморазвитие» уже сумел зацепить ваше внимание своим уникальным стилем или подачей. А мы на RUVIDEO позаботились о том, чтобы вы могли изучить весь архив его работ в максимально комфортных условиях — без лишней суеты и преград.
Почему за работами канала «Тайное саморазвитие» так интересно наблюдать? Всё просто: это честный контент, который находит отклик в сердцах зрителей. На нашем ресурсе вы можете смотреть онлайн все видео любимого автора бесплатно и в хорошем качестве. Нам важно, чтобы вы видели каждую деталь и слышали каждый нюанс, поэтому мы используем только стабильные плееры из открытых источников Rutube.
Следите за новинками канала, пересматривайте старые шедевры и открывайте для себя новые грани творчества «Тайное саморазвитие». Мы постоянно обновляем ленту, чтобы у вас под рукой всегда были самые свежие выпуски. Никаких сложных регистраций — только вы и творчество, которое вдохновляет. Приятного вам путешествия по миру авторского контента на RUVIDEO!
Видео взято из открытых источников Rutube. Если вы правообладатель, обратитесь к первоисточнику.